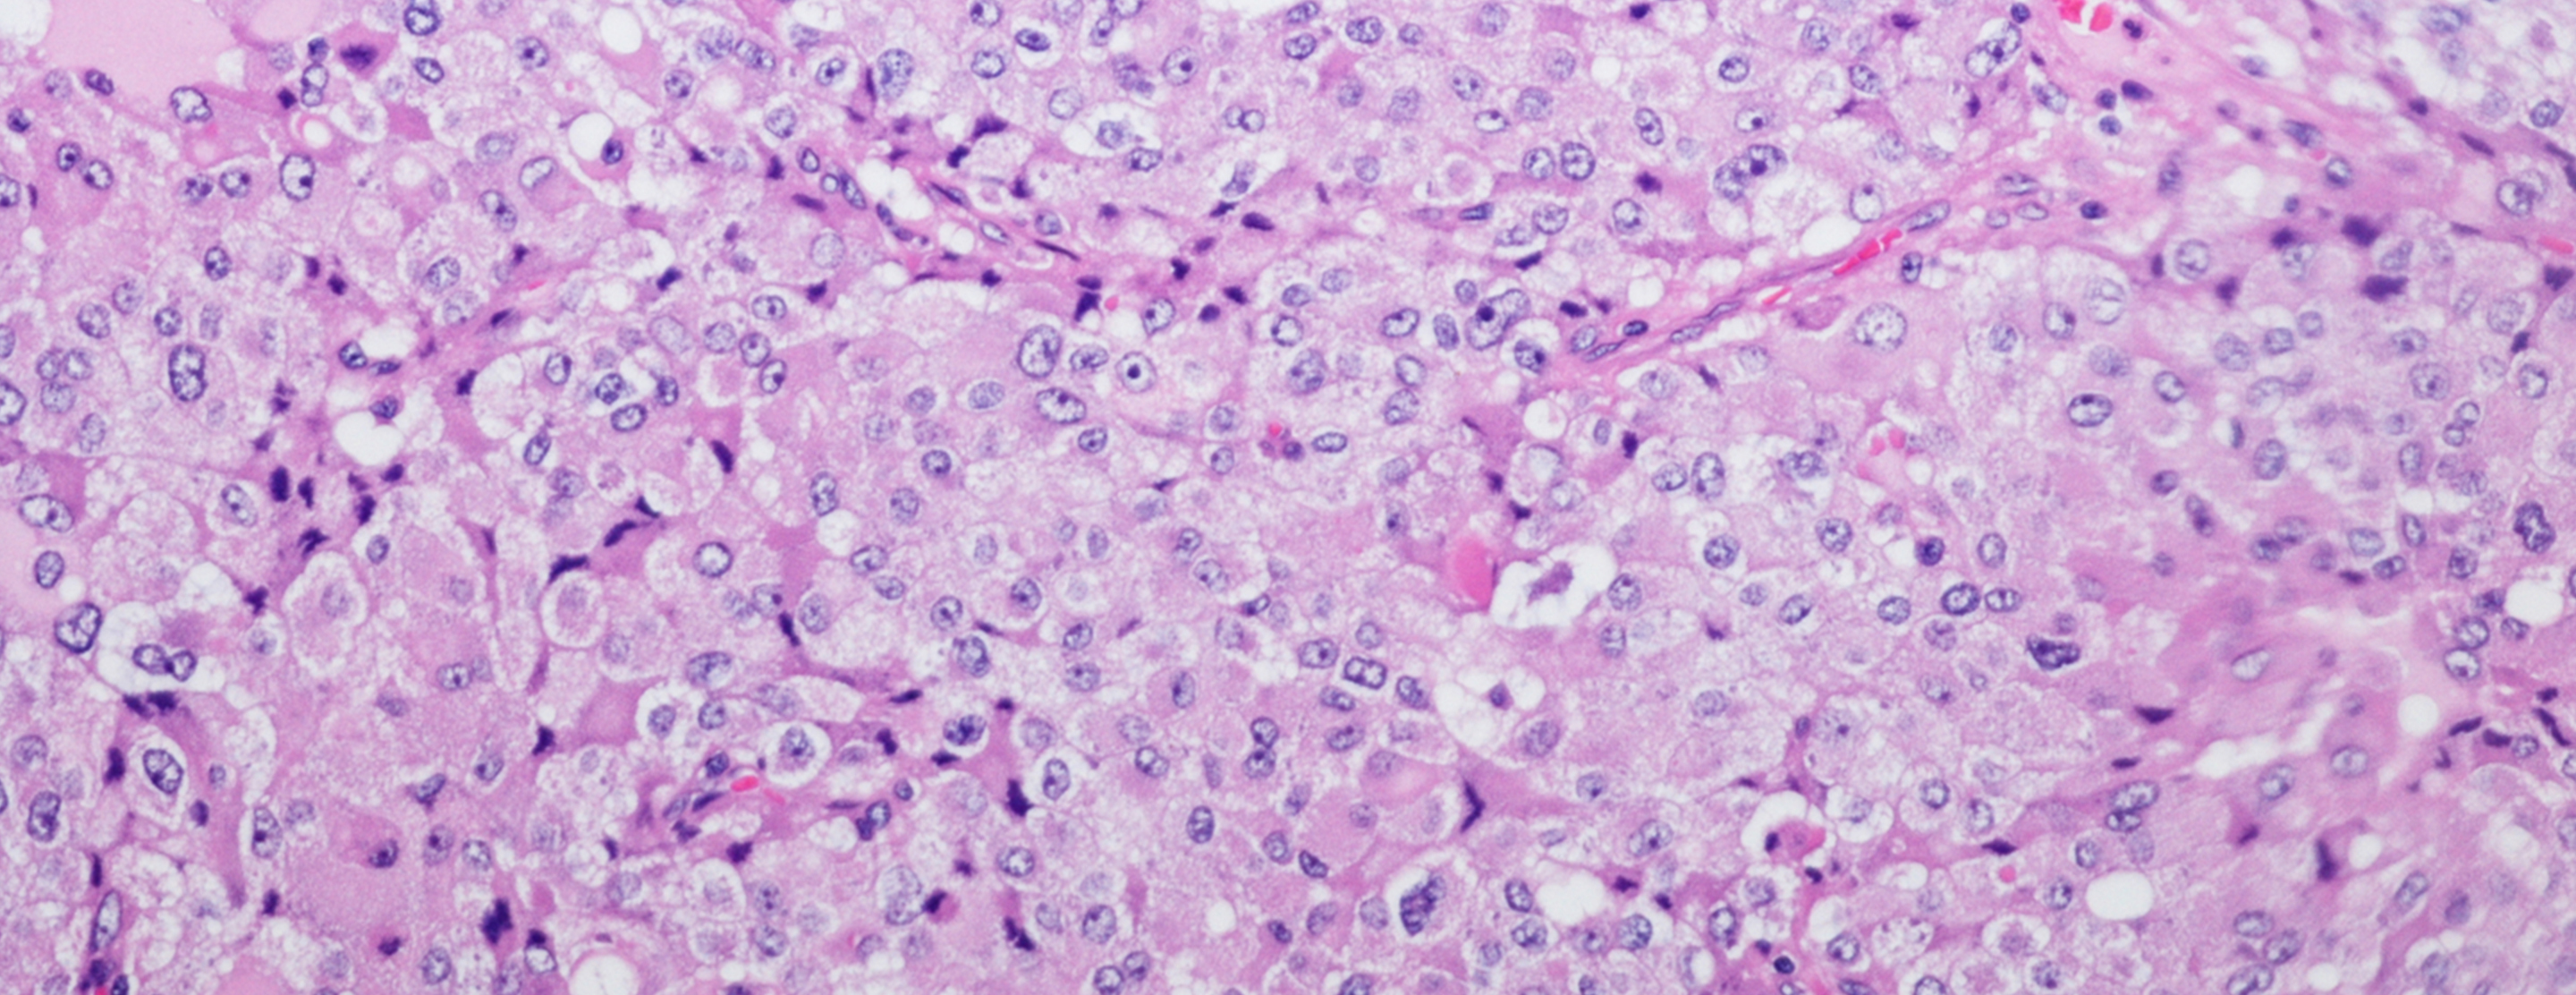

MIBG scintiscan
Definition
An MIBG scintiscan is a type of imaging test. It uses a radioactive substance (called a tracer). A scanner finds or confirms the presence of
Alternative Names
Adrenal medullary imaging; Meta-iodobenzylguanidine scintiscan; Pheochromocytoma - MIBG; Neuroblastoma - MIBG; Carcinoid MIBG
How the Test is Performed
A radioisotope (MIBG, iodine-131-meta-iodobenzylguanidine, or iodine-123-meta-iodobenzylguanidine) is injected into a vein. This compound attaches to specific tumor cells.
You will have the scan later that day or the next day. For this part of the test, you lie on a table under the arm of the scanner. Your abdomen is scanned. You may need to return for repeated scans for 1 to 3 days. Each scan takes 1 to 2 hours.
Before or during the test, you may be given an iodine mixture. This prevents your thyroid gland from absorbing too much of the radioisotope.
How to Prepare for the Test
You will need to sign an informed consent form. You will be asked to wear a hospital gown or loose-fitting clothes. You will need to remove jewelry or metal objects before each scan. Many drugs interfere with the test. Ask your health care provider which of your regular medicines you may need to stop taking before the test.
How the Test will Feel
You will feel a sharp needle prick when the material is injected. The table may be cold or hard. You must lie still during the scan.
Why the Test is Performed
This test is done to help diagnose pheochromocytoma. It is done when an
Normal Results
There are no signs of a tumor.
What Abnormal Results Mean
Abnormal results may indicate:
Pheochromocytoma Multiple endocrine neoplasia (MEN) II - Carcinoid tumor
- Neuroblastoma
Risks
There is some exposure to radiation from the radioisotope. The radiation from this radioisotope is higher than from many others. You may need to take extra precautions for a few days after the test. Your provider will tell you what actions to take.
Before or during the test, you may be given an iodine solution. This will keep your thyroid gland from absorbing too much iodine. Usually people take potassium iodide for 1 day prior and 6 days after. This blocks the thyroid from taking up the MIBG.
This test should not be done on pregnant women. The radiation can pose danger to the unborn baby.
References
Bleeker G, Tytgat GAM, Adam JA, et al. 123I-MIBG scintigraphy and 18F-FDG-PET imaging for diagnosing neuroblastoma. Cochrane Database Syst Rev. 2015;(9):CDC009263. PMID: 26417712
Cohen DL, Fishbein L. Secondary hypertension: pheochromocytoma and paraganglioma. In: Bakris GL, Sorrentino MJ, eds. Hypertension: A Companion to Braunwald's Heart Disease. 3rd ed. Philadelphia, PA: Elsevier; 2018:chap 15.
Oberg K. Neuroendocrine tumors and related disorders. In Melmed S, Auchus RJ, Goldfine AB, Koenig RJ, et al, eds. Williams Textbook of Endocrinology. 14th ed. Philadelphia, PA: Elsevier; 2020:chap 45.
Yeh MW, Livhits MJ, Duh Q-Y. The adrenal glands. In: Townsend CM Jr, Beauchamp RD, Evers BM, Mattox KL, eds. Sabiston Textbook of Surgery. 21st ed. Philadelphia, PA: Elsevier; 2022:chap 40.
Review Date: 07/05/2022
The information provided herein should not be used during any medical emergency or for the diagnosis or treatment of any medical condition. A licensed physician should be consulted for diagnosis and treatment of any and all medical conditions. Call 911 for all medical emergencies. Links to other sites are provided for information only -- they do not constitute endorsements of those other sites. Copyright ©2019 A.D.A.M., Inc., as modified by University of California San Francisco. Any duplication or distribution of the information contained herein is strictly prohibited.
Information developed by A.D.A.M., Inc. regarding tests and test results may not directly correspond with information provided by UCSF Health. Please discuss with your doctor any questions or concerns you may have.